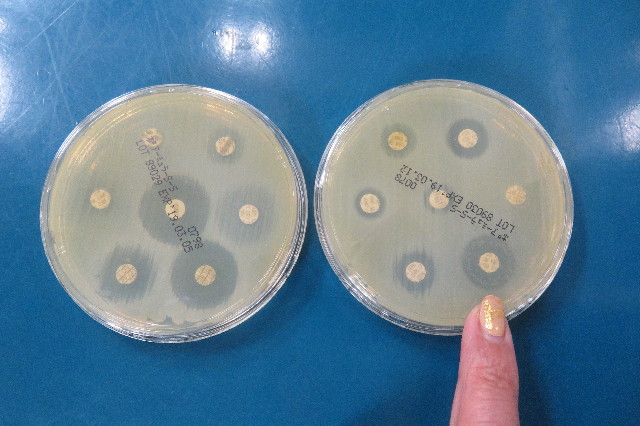
ファイル 6764-1.jpg

おとといの晩おしっこのところから茶色い膿が出てしまい、
昨日腟炎と診断。(発端は膀胱炎によるものかも)
このくらいなら薬漬けにはしたくないので薬は飲まないことにしましょうとなったのですが、
今日の午後のおしっこ、続けて2回鮮血が出てしまったので獣医さんに電話しました。
トイレシーツを持って獣医さんにママだけ行ったところ、ヒートによる出血ではないし、『茶色い膿』を培養していたところ、まだ途中だけれど菌も生えて薬も選べるし、今回は出血してしまったので薬を飲みましょうということに。
(電話しないで様子を見るという手もあったかも?(^^ゞ)
右のよく効くニューキノロン系はとっておいて、
今回の膿には、次に効き目のあるダイフェンを飲むことになりました。
●抗生物質のダイフェンを1日2回、1回1.5粒と、
●抗生物質で下痢しないためにビオフェルミンを1日2回、1回1錠
●院長が体質改善をしないととおっしゃるので、何かありますか?ときいて、ユベラNカプセル100mを1日2回、1回2カプセルのむことになりました。
通常は高血圧などに使うお薬のようですが?、
もには、『ビタミンEの抗酸化作用で、炎症を起こさせないようにする』のを狙いとして飲ませるとのことです。(ママの記憶が正しければ)
まっ、今回は抗生物質をきっちり飲ませてみて、その後はユベラに期待しましょう!
もちろん、“もにちゃん”に頑張ってもらいつつ、ママもモミモミなどでちゃんと協力しますよー(*゚Ω゚)/ウィッス!!
おまけ写真
外でちっとも待てない“もにちゃん”ですが、ロングリードをつけて待ての練習をしてみました!
まずは柵にロングリードをつないで、ママと一緒にフラフラとあたりりを散策。
次に美味しいお肉を見せて、『待て』をかけてママが離れます。
最初はすぐに動いてママについてきてしまいましたが、美味しいお肉欲しさに、あっという間にできるようになりましよ(^_-)-☆
最後に、普通のリードに戻して、ちょっとドキドキしながらこのくらいだけ離れてみました。
...(ほんの数秒しかしていないですが)ちゃんと『待て』できた良い子の“もにちゃん”でーす★('-^v)
明日もできるかな?
家でのごはんの時の待ては、完璧にできますよ。
お出かけや車の乗り降り、お散歩、人やワンちゃんと接する時等々、『待て』がきちんとできるかできないかは、今後の安全な生活にすごく重要なことだからしっかりできるといいですよね!